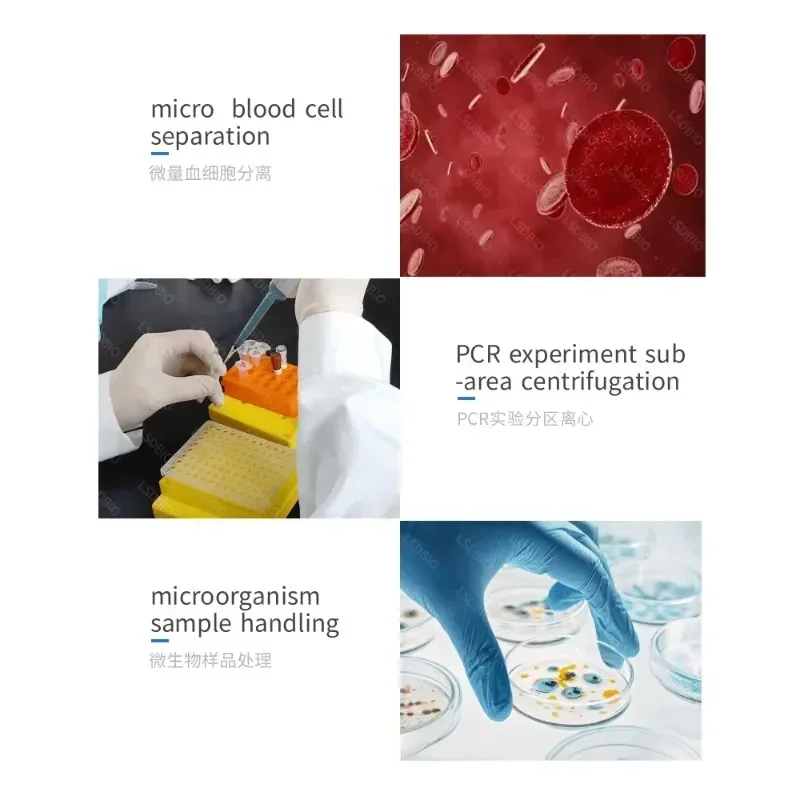
thumb

Lab MiniL-7G/MiniL-12G Medical Laboratory High Speed Refrigerated Medical Machine Laboratory Centrifuge
Price history chart & currency exchange rate
Customers also viewed

$18.32
Fashion New Casual Business Belt Men's Luxury Brand Design Korean Version Golf Lychee Pattern Leather Automatic Buckle Belt A931
aliexpress.com
$20.91
Nail Puller Tool Cats Remover Pry Bar Paw Extractor Household Carbon Steel Claw Home Multi Mini
aliexpress.com
$35.25
AAA Fashion Men's Business Style Original Brand Stainless Steel Watch Quartz Movement Three-eye Display Waterproof Function Hot
aliexpress.com
$59.46
Global Smart Voice Translator Offline Various Language Simultaneous Translation Pen Artifact Voice Business Dictionary Pen Best
aliexpress.com
$23.90
Suction Cup Car Phone Holder Professional Shooting Video Phone Metal Holder Support iPhone 13 12 11 Pro Xiaomi Huawei Samsung
aliexpress.com
$45.70
Женские Меховые Туфли на танкетке, модные роскошные босоножки с высоким голенищем, повседневные теплые меховые танкетки на среднем каблуке, сандалии на осень-зиму
aliexpress.com
$580.00
Bicycle Carbon Bike 29er Hardtail Mountain Complete Bike Carbon Frame XC MTB XT M8100 Groupset 12 Speed Bicycle Carbon Wheels
aliexpress.com
$130.65
Highlight Wigs Human Hair 13x6 Hd Lace Frontal Wig Highlight Wig Lace Frontal Human Hair Wigs Straight Lace Front Wig For Women
aliexpress.com
$24.28
22Pcs Steam Mop Cloth Cleaning Pad Cloth Cover For KARCHER SC Series SC1/SC2/SC3/SC4/SC5 Steam Cleaner
aliexpress.com
$84.40
KeyTok OEM Profile Pixel Universe Doubleshot Dye Sub Keycap Set thick PBT for keyboard 87 tkl 104 ansi bm60 CSTC75 BM87 BM65
aliexpress.com
$14.54
Portable Pet Dog Water Bottle For Small Large Dogs Travel Puppy Cat Drinking Bowl Outdoor Pet Water Dispenser Feeder wiht shovel
aliexpress.com
$14.46
BC49AQ New Car Bluetooth MP3 Car FM Transmitter QC3.0 Ambient Light Voice Assistant
aliexpress.com
$54.67
Новинка лета 2, мужская обувь, Корейская версия тенденции 9, мужская повседневная обувь HHA3C5
aliexpress.com
$56.40
Hu-a Wei 10GB 40KM SFP Optical Switch 34060518 S4017567 10G-1550NM-40KM-SM-SFP+ Single-Mode 40KM Optical Transceiver
aliexpress.com
$4.42
2023 Summer Lovely Unicorn Graphic Print Kid's Cartoon Fashion Short Sleeve T shirt 4-14T Size Fit 4-14 Years Old Kids
aliexpress.com
$0.67
Comptible for VFD35M106IIE LD35-1/P WD35MII-2006 Midea Microwave Oven Parts/Accessories Timer Controller 15A/250VAC
aliexpress.com
$2.16
Curtain Rod Bracket Hooks Seamless Adjustable Clear Wall Bracket Self Adhesive Rods Hanger For Home Bearing Curtain Hooks
aliexpress.com
$23.42
304 Stainless Steel Solar PV Photovoltaic Side Mounting Bracket Height Adjustable Tile Roof Hooks Holder Installation Tools
aliexpress.com
$19.03
Бак для аквариума, бетта, украшения в виде бревен, украшение для дерева, набор из бревен, форма отверстия, корень, полый полимер
aliexpress.com
$16.00
LCD for LG G5 LCD Original 5.3" Display For LG G5 LCD H850 H840 H860 H820 Touch Screen Digitizer Assembly WITH FRAME Replacement
aliexpress.com
$238.06
original edition shoulder berkins designer bag h home handbags litchi grain leather with logo handheld women fashion hand business simplicit
dhgate.com
$29.43
Designer backpack Knapsack book bag Luxury Brand Bags double G Ophidia Purse back pack shoulder straps backpacks Women's men's Leather travel Satchels Purses Lvs GGs, Brown floral
dhgate.com
$5.49
Кондиционер Экспресс-восстановление Express reconstruction conditioner (ПК107, 100 мл)
kosmetika-proff.ru
$55.44
Newest 2In1 IPL Epilator Permanent Hair Removal LCD Display Depilador Bikini Trimmer Photoepilator
aliexpress.com
$1.93
Cosplayer Mouth Face Mask 3D Printing Fabric mascaras Protective PM 2.5 Carbon Filter Mouth-Muffle Dust Washable Reusable Masks
aliexpress.com
$22.44
waist trainer for women sauna sweat thermo sport shaper belt slim sports waist belt shaper underwear, Black;white
dhgate.com